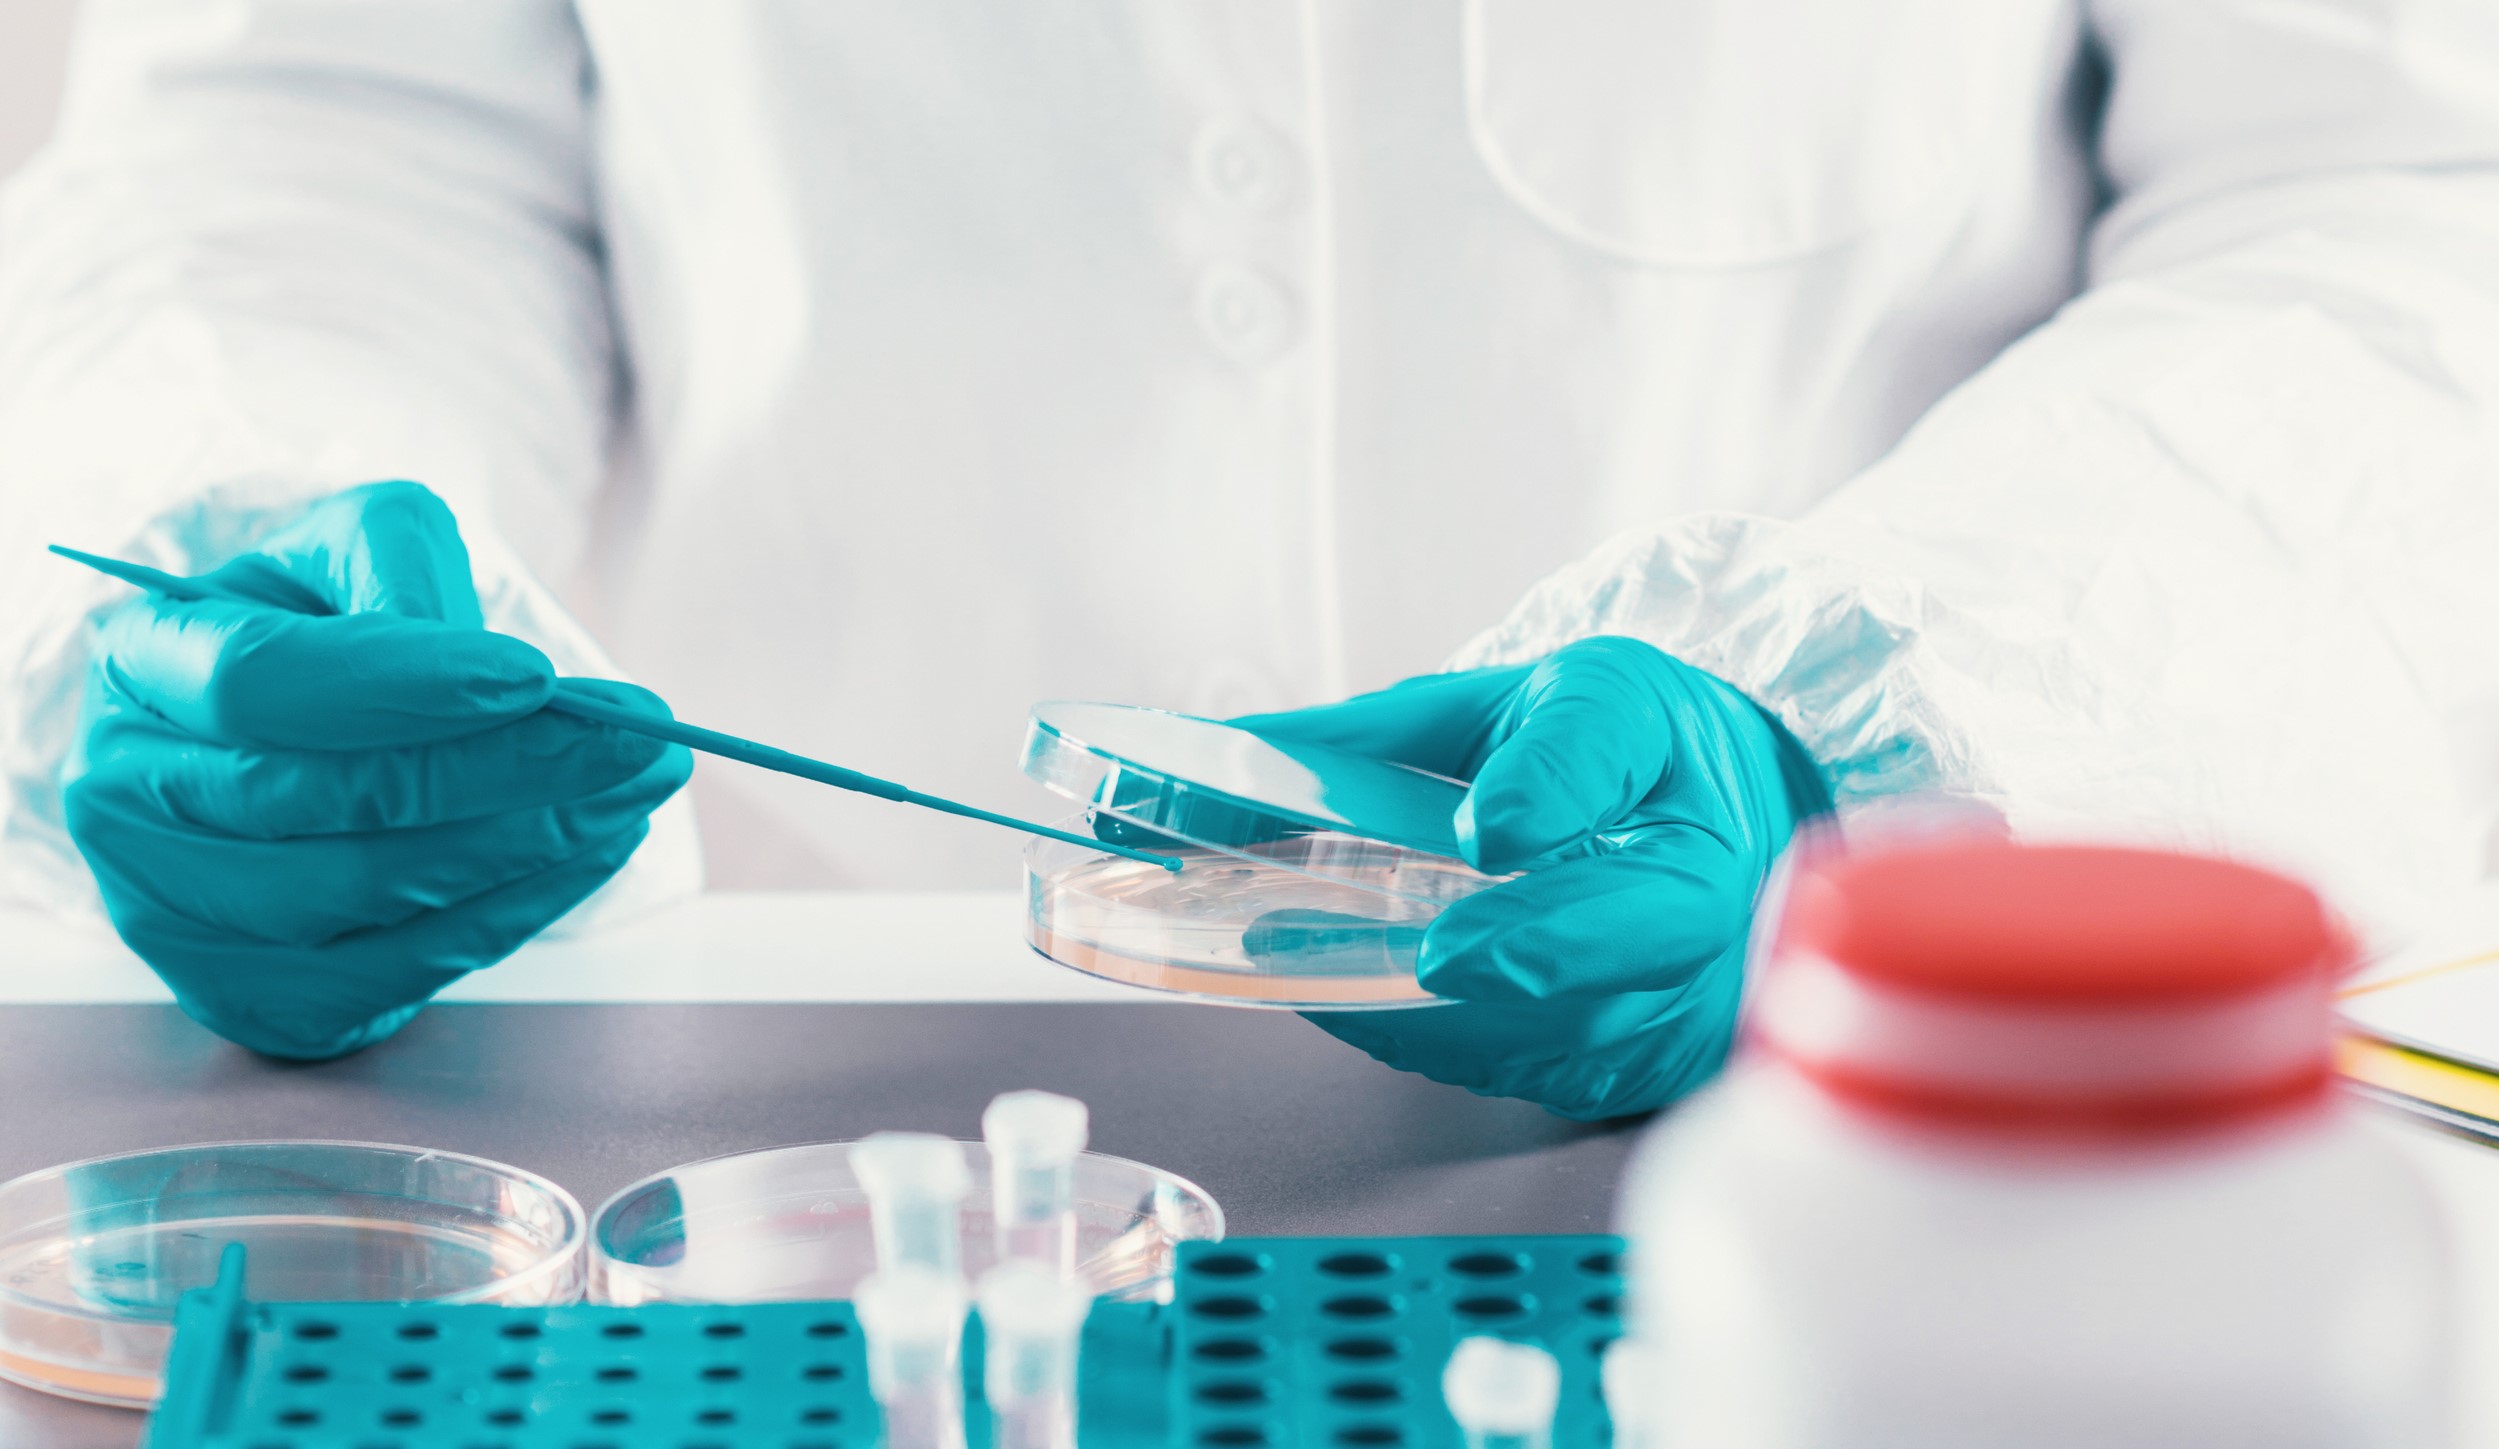

As the headlines continue to show the effects of the Coronavirus worldwide, concerns of how a commercial insurance policy will respond are on the rise. Coverage varies greatly by carrier, but here is what we know:
- Virus is commonly excluded from coverage.
- Property and business income policies only provide coverage if there is first a direct physical loss to property by a covered peril.
- Even if civil authority mandates a business closure, there must still be loss to property by a covered peril for coverage to respond.
- The industry is responding to the Coronavirus and evaluating ways to provide coverage in the future if similar events occur.
We are on top of this and continue to monitor the industry and its response moving forward. No timeline has been established for when, or if, there will be a permanent solution for this event in a commercial insurance policy. We will communicate updates as they become available.
In the meantime, we are here to answer questions as they relate to your policy.